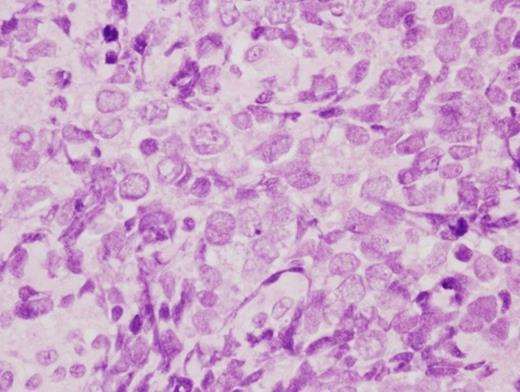

-
PDF
- Split View
-
Views
-
Cite
Cite
A Sugamata, K Goya, N Yoshizawa, A case of complete spontaneous regression of extremely advanced Merkel cell carcinoma, Journal of Surgical Case Reports, Volume 2011, Issue 10, October 2011, Page 7, https://doi.org/10.1093/jscr/2011.10.7
Close - Share Icon Share
Abstract
Merkel cell carcinoma (MCC) is a rare locally malignant cutaneous tumor of neuroendocrine origin, most often occurring on the head and neck of the elderly. MCC is a highly aggressive tumor with a high percentage of recurrence, metastatic spread and mortality. Despite the highly malignant course of MCC, there have been several reports of spontaneous regression or resolution. We report the clinical course of a 71-year-old man with MCC. The tumor initially occurred in the left lower eyelid and advanced to encompass nearly half the face. Despite its large size, complete spontaneous regression of the tumor occurred. This is the most advanced case of complete spontaneous regression of MCC to be reported.
INTRODUCTION
Merkel cell carcinoma (MCC) is a neuroendocrine tumor with a high rate of local recurrence and regional lymph-node metastases (1). We report the clinical course of one man with advanced MCC, which initially occurred in the left lower eyelid and regressed spontaneously.
CASE REPORT
A 71-year-old man presented with a nodular lesion on his left lower eyelid. Clinical examination revealed a reddish-pink, firm, dome-shaped 8×6 mm nodule (Figure 1). The lesion was excised with a 2 mm margin for histopathology. Histological examination showed groups of small cells with large nuclei and small cytoplasms in the dermis, with abnormal mitoses (Figure 2).

Clinical examination revealed a reddish-pink, firm, dome-shaped nodule measuring 8×6 mm
Histological examination showed groups of small cells with large nuclei and small cytoplasms in the dermis (H.E. ×200)
Immunohistochemical staining was positive for cytokeratin 20, CD56, synaptophysin and chromogranin A, and negative for S-100 protein, desmin, CD99, CD20, CD30, CD45RO, CD79a, TTF-1 and CK7. The histopathological diagnosis was MCC. Two weeks after the first operation, the initial surgical margin was deemed insufficient, and an additional excision of the skin and muscle around the scar was performed with a 1.5 cm margin to ensure negative margins. The lesion was covered with the local flap. The edge of the excised tissue was negative of tumor invasion. Seven weeks after the second operation, a small nodule developed in the left preauricular region and was excised under local anesthesia. Histopathological examination determined this to be metastasis of MCC. The primary and the metastatic cervical regions received a total of 50 Gy linac X-ray.
Three weeks after the last radiation treatment, a new recurrence of MCC developed in the left lower eyelid, and MRI revealed tumor invasion into the maxillary sinus (Figure 3).

Five months after the first examination, a recurrence of MCC developed in the left lower eyelid
There were no distant metastases. Six months after the first examination, total maxillo-orbitotomy with radical neck resection was performed. The resultant defect was covered with a free rectus abdominis musculocutaneous flap. The surgical stumps of excised tissue were all negative of tumor invasion, and there were no cervical lymph node metastases. Two months after the expanded excision, MCC recurred around and on the flap. Chemotherapy with paclitaxel, cisplatin, and fluorouracil was administered in four doses with concurrent radiotherapy (linac 50 Gy); however, the recurrent MCC had progressed and came to occupy half the area of the face by 8 months after the initial presentation (Figure 4).

Ten months after the second operation, the recurrent MCC had advanced over almost half of the facial area
At this advanced stage (Stage 2C by the current AJCC staging system) there was no option for further treatment. However, 4 months after the last chemotherapy, signs of spontaneous regression could be seen in every region of the tumor. Follow-up clinical and MRI examinations over 3 months from the beginning of spontaneous regression revealed complete regression of the MCC (Figure 5). There has been no local recurrence or distant metastasis of MCC in 2 years since total regression.

Three months after the beginning of regression, the tumor had completely disappeared
DISCUSSION
MCC is a rare cutaneous carcinoma of neuroendocrine origin. It is highly aggressive with a high percentage of recurrence, metastatic spread and mortality. Treatment of metastasized or recurred MCC is not clearly standardized and prognosis is often poor. Despite the highly malignant course of MCC, there have been over twenty reports of spontaneous regression or resolution of this tumor (1-4). The mechanism of spontaneous regression is unclear and may be explained by immune-mediated phenomena, cellular sequences, and other microenvironmental interactions, including a possible role of histiocytes in tumor elimination (4). A recent study showed that patients with Merkel cell polyomavirus (MCV) positive MCC had a better overall survival than patients with MCV negative MCC (5). Although further studies are needed, we can speculate that MCV may have a relationship with spontaneous regressions. Complete spontaneous regression of MCC has been described both in patients with primary local disease and in patients with recurrences or metastasis. In local disease, spontaneous regression occurred after the biopsy was performed. In the second group with recurrences or metastasis, spontaneous regression in MCC occurred without a clear trigger (4). Additionally, among patients who have frequent recurrences and metastases, spontaneous regressions occurred at all tumor locations simultaneously (2,4). Cases of spontaneous regression in multiple MCC occurred where there were relatively small skin sites or metastatic lymph nodes (3,4). No case of complete spontaneous regression involving such a large, advanced tumor as in this case has been reported. No evidence of local recurrence or metastasis has been documented during follow-up after spontaneous regression (3,4), which may indicate that a recurrence in this patient is unlikely. Stage of disease has been shown in a recent study to be the best predictor of survival. In the treatment of the MCC, the possibility of spontaneous regression should be kept in mind and physicians should continue providing decisive treatment, even to patients whose condition is advanced.